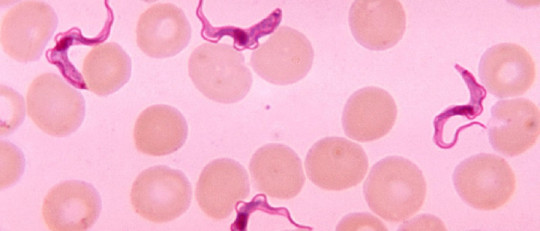
Enfermedad del sueño

El ser humano no nace solo y aislado. Venimos al mundo en un contexto concreto, rodeados de otras personas que pertenecen a nuestra familia, nuestra sociedad y nuestra cultura que van a marcar en gran medida cómo nos desarrollamos, nuestros valores y nuestras formas de pensar y actuar.
Somo seres gregarios, que conviven con otros miembros de la misma especie en agrupaciones más o menos extensas. Es por ello que resulta de gran utilidad conocer los mecanismos que operan dentro de los grupos. Dichos estudios sobre los grupos es llevado a cabo por una parte de la psicología social llamada psicología de los grupos.
Una breve definición de la Psicología de los Grupos
La psicología de los grupos es una sub-disciplina dentro de la psicología social cuyo principal objeto de estudio es el grupo. Este es analizado desde la óptica de la influencia que tiene el grupo sobre el comportamiento individual y la que tiene el individuo a la hora de modular el comportamiento del colectivo.
Así, desde la psicología de los grupos se exploran qué son, cómo, cuándo y dónde se crean, su configuración y los tipos de roles y relaciones que se establecen entre sus elementos o con otros grupos.
- Artículo relacionado: "Las 12 ramas (o campos) de la Psicología"
El grupo como objeto de estudio
Como hemos dicho, la psicología de los grupos tiene al grupo como objeto de estudio. Pero... ¿qué es un grupo? Si bien el significado de este término puede parecer obvio, lo cierto es que a la hora de definir su objeto de estudio la psicología de los grupos o grupal ha encontrado complejo definir los límites entre qué es y que no es un grupo.
De manera general, podemos definir un grupo como un conjunto de individuos independientes que tienen una percepción colectiva y compartida de su unidad y que siendo conscientes de ésta son capaces de actuar de manera conjunta ante el entorno. Dicha vinculación provoca que haya relaciones de influencia e interdependencia entre sus diversos componentes, afectando al grupo el comportamiento del individuo y viceversa. Además la relación existente con el grupo es por lo general observada como positiva.
Autores principales
Algunos de los representantes más importantes de la psicología de los grupo son Kurt Lewin y Jacob Levy Moreno. El primero, con su Teoría de Campo, trataba de dar una explicación sobre los procesos psicosociales que se llevan a cabo en los grupos, mientras que el segundo, que además fue el creador del psicodrama, daba mucha importancia a la necesidad de organizarse en colectivos para dar respuesta a necesidades grupales.
Temáticas en las que se trabaja
Dentro de la psicología grupal existen numerosos aspectos que se pueden trabajar, y estos son los que conforman las funciones de esta rama de la ciencia de la conducta. Tanto a nivel estructural como funcional, el grupo es un elemento complejo en el que participan diferentes variables y procesos.
Algunas de las múltiples temáticas en las que se investiga y participa desde la psicología de los grupos son las siguientes
1. Tipos de agrupación
No todos los grupos son iguales. De hecho, podemos encontrar un gran número de tipologías de ellos según las características de las personas miembro o porqué o con qué objetivo se forman.
Una de los clasificaciones más importantes a destacar es la existencia de grupos primarios, en que los sujetos interactúan cara a cara generándose un fuerte arraigo emocional y una intimidad y identificación que hace que duren en el tiempo, y secundarios o más dirigidos a un objetivo específico sin necesitar un contacto continuado.
Destaca también la existencia de grupos de pertenencia, de los que el sujeto forma parte de forma involuntaria por características o circunstancias ajenas a su control o deseo. Por otro lado también pueden encontrarse grupos de referencia, entendidos como aquellos grupos a los que el individuo elige adscribirse por preferencia o coincidencia en valores, pensamientos o creencias.
Otras tipologías las podemos encontrar vinculadas al tamaño, siendo grupos pequeños los menores de veinte componentes y grandes los que superan dicho número, o al hecho de que se constituyan de manera prevista o imprevista y el tipo de relación que mantengan entre sí sus miembros, como ocurre con los grupos formales o informales.
2. Estructura básica
La manera en que se organiza el grupo es un elemento fundamental a la hora de entender cómo y por qué funciona. Es por ello que desde la psicología de los grupos se investigan diversas variables, desde el tamaño del grupo a la presencia de liderazgo e influencia.
3. Funciones del grupo
Conocer cómo funcionan los grupos o como se estructuran resulta de gran interés para la psicología de los grupos. Sin embargo, no hay que olvidar analizar el motivo por el cual se forma o que lleva a éste.
De este modo la psicología de los grupos pretende también focalizarse en qué objetivos tienen los grupos como tales o qué buscan los individuos a la hora de formar parte de uno, junto a cómo interactúan las metas individuales y grupales. Así, fenómenos como la atracción hacia las personas, ideas o actividades propuestas por el grupo, la búsqueda de pertenencia a un grupo o las necesidades individuales que se pretenden suplir mediante la unión al colectivo serán aspectos detenidamente estudiados por esta rama de la psicología.
4. El poder: liderazgo
Las relaciones de poder dentro del grupo es otro de los elementos estudiados por la psicología de los grupos. Y es que el poder y la capacidad de influir sobre los demás es una constante en cualquier tipo de colectivo.
La presencia de un líder o de un grupo de individuos que marquen el camino que debe seguir el grupo es relativamente frecuente, si bien no imprescindible, especialmente cuanto mayor es el número de componentes del grupo y cuando hay un objetivo a cumplir. Cómo se llega al liderazgo y de qué manera se ejerce éste son temáticas de gran relevancia en este aspecto.
Dentro de las relaciones de poder también se analiza el concepto de autoridad y la obediencia respecto a ésta.
- Artículo relacionado: "Tipos de Liderazgo: Las 5 clases de líder más habituales"
5. Relaciones de influencia
No siempre que se establece un grupo es necesaria la presencia de alguien concreto que marque qué, cómo o cuándo deben hacerse o pensarse determinadas cosas. Sin embargo, el hecho de pertenecer a un colectivo implica de por sí que va a haber una interrelación del algún tipo entre sus componentes. Dicha interrelación va a hacer que el uno tenga un efecto sobre el otro, constituyéndose redes de influencia de gran relevancia en la modificación de actitudes y creencias.
Para la psicología de los grupos este es un apasionante campo de investigación, en el que exploran aspectos como la conformidad con el grupo, la influencia que tienen las opiniones del grupo sobre la propia y el porqué de ésta o como algunos individuos y minorías son capaces de hacer cambiar la percepción mayoritaria. Del mismo modo son relevantes los procesos mediante el cual el grupo motiva a sus miembros
También la toma de decisiones colectiva es un aspecto a tener en cuenta, dependiendo en gran medida de la influencia y rol de cada miembro y del conjunto del colectivo. En este aspecto se ha demostrado que el colectivo tiende a ser más extremista que el individuo, a través del proceso de polarización grupal. Una forma extrema de ello es el pensamiento grupal, en el que se tiende a pensar que todos los individuos que forman parte del grupo opinan del mismo modo y que éste es el correcto, hasta un punto que puede llegar a tergiversar la realidad y perseguir activamente la disidencia.
- Quizás te interese: "El Experimento de la Prisión de Stanford de Philip Zimbardo"
6. Efectos del grupo sobre el individuo
Formar parte de un grupo tiene una serie de consecuencias claras para el individuo. Pasando por la adquisición de conocimientos y la modificación de actitudes y creencias a incrementar o reducir mediante facilitación o inhibición social el rendimiento de su actividad, este elemento ha de tenerse muy en cuenta tanto desde la psicología más individual como desde la psicología de los grupos.
7. Efectos del individuo sobre el grupo
Al igual que el grupo tiene un efecto sobre el individuo, éste tiene un efecto sobre el grupo. No hemos de olvidar que el grupo es un colectivo conformado por diferentes sujetos que son susceptibles a modificaciones, de manera que la forma de proceder o pensar de uno de sus miembros puede suponer una alteración de todo el sistema. Ello es visible en el antes citado liderazgo, o en el aumento o disminución de la motivación y polarización que puede llegar a producir un individuo de forma directa o indirecta.
8. Ciclo vital del grupo
Un grupo no aparece de la nada de manera espontánea, ni es un todo que permanece inmutable a lo largo del tiempo. La psicología de los grupos es consciente de estos hechos, estudiando los procesos que conllevan a la formación y disolución de los grupos. Desde la adscripción e identificación con el grupo hasta la presencia de un declive, descontento y ruptura, estas fases suponen un campo de investigación que puede permitir aplicar diferentes técnicas y estrategias sobre colectivos concretos
9. Salud del grupo
La forma en que se relacionan los componentes del grupo es fundamental para que un grupo permanezca unido, o que por lo contrario se disuelva. La atracción interpersonal, la coincidencia de metas, la cohesión del grupo, la reciprocidad y el compromiso son algunos de los elementos que contribuyen a explicar la salud del grupo.
10. Los roles
El papel de cada sujeto dentro de un grupo es lo que se define como su rol. Este establece cómo se espera que se comporte y el tipo de actividades que va a realizar. El rol puede ser autoimpuesto o venir fijado por el entorno, pudiendo vivirse de manera egosintónica o egodistónica. Participa en fenómenos como el poder y el nivel de influencia, la capacidad para seguir o obviar normas y la manera en que se relaciona cada individuo con todos los miembros del grupo y con el resto del mundo.
11. La comunicación
La manera en que se produce la transmisión de diversos estímulos entre los diferentes componentes de un grupo puede explicar fenómenos como la influencia, la satisfacción y el nivel de cohesión interna. Mediante la comunicación se va a negociar la visión común respecto al mundo, los objetivos y el papel de cada uno en comunidad. Es por ello que estudiar cómo nos comunicamos es un factor imprescindible para la psicología de los grupos.
12. Relaciones con otros grupos e individuos
Por norma general un grupo no permanece aislado del resto del mundo. El grupo se encuentra situado en un contexto determinado en el que se va a encontrar con otras personas y agrupaciones ajenas a sus componentes, y con el que de una manera u otra va a interactuar tanto a nivel grupal como a nivel de cada uno de sus miembros.
Estas interacciones son también una parte muy importante de la psicología de los grupos, la cual se va a centrar especialmente en el tipo de contacto establecido, la creación de barreras más o menos permeables entre endogrupo y exogrupo y la colaboración, competición o conflicto entre colectivos según sus metas sean compatibles.


Newsletter PyM
La pasión por la psicología también en tu email
Únete y recibe artículos y contenidos exclusivos
Suscribiéndote aceptas la política de privacidad